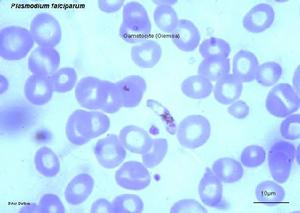
原生動物

簡介

原生動物
主要特徵
 原生動物
原生動物從細胞結構上看,原生動物的單細胞相似於多細胞動物身體中的一個細胞,也可以區分成細胞質(cytoplasm)及細胞核(nucleus),細胞質表面有細胞膜(cellmembrane)包圍。從機能上看,(原生動物)細胞又是一個完整的有機體,它能完成多細胞動物所具有的生命機能,例如營養、呼吸、排泄、生殖及對外界刺激產生反應,這些機能由細胞或由細胞特化而成的細胞器(organelles)來執行。所以不同的細胞器在機能上相當於多細胞動物體內的器官及系統。它們是在不同的結構水平上執行著相同的生理機能。原生動物在結構與機能上分化的多樣性及複雜性是多細胞動物中任何一個細胞無法比擬的,所以從細胞水平上說,構成原生動物的細胞是分化最複雜的細胞。極少數原生動物是由幾個或許多個細胞組成,細胞之間沒有形態與機能的分化,也可能出現了初步的形態機能分化,但每個細胞仍然保持著一定的獨立性,這類原生動物稱為群體(colony),例如盤藻(Gonium)、雜球藻(Pleodorina)等。
(二)大小與體形
大多數的原生動物體長在300μm以下,例如草履蟲(Paramoecium),在150—300μm之間。最小的種類體長僅有2—3μm,如利什曼原蟲(Leishmania),大型的種類體長可達7cm,例如海產的某些有孔蟲類(Foraminifera),淡水生活的鏇口蟲(Spirostomum)3mm,新生代化石錢幣蟲(Nummulites)竟達19cm,這是原生動物在個體大小上曾經達到過的最大記錄。原生動物的體形隨種及生活方式表現出多樣性:一些種類身體沒有固定的形態,身體的表面只有一層很薄的原生質膜(Plasmalemma),因而能使細胞的原生質流動而不斷地改變體形,例如變形蟲(Amoeba)。多數的種類有固定的體形。眼蟲(Euglena)由於體表的細胞膜內蛋白質增加了厚度及彈性形成了皮膜(pellicle),使身體保持了一定的形狀。皮膜的彈性使身體可以適當的改變形狀。衣滴蟲(Chlamydomonas)的細胞外表是由纖維素及果膠組成,因而形成了和植物一樣的細胞壁,體形不能改變。
原生動物的體形與生活方式相關,例如固著生活的種類,身體多呈錐形、球形,有柄,柄內有肌絲纖維,可使蟲體收縮運動,鐘形蟲(Vorticella),足吸管蟲(Podophrya)就是這種體形。漂浮生活的種類,身體多呈球形,並伸出細長的偽足,以增加蟲體的表面積,例如輻射蟲(Actinosphaerium)及某些有孔蟲。營游泳生活的種類,身體呈棱形,例如草履蟲(Paramoecium)。適合於底棲爬行的種類,身體多呈扁形,腹面纖毛聯合形成棘毛用以爬行,例如棘尾蟲(Stylonychia)。營寄生生活的種類或者失去了鞭毛,如利什曼原蟲,或者鞭毛借原生質膜與身體相連形成波動膜(undulatingmembrane),以增加鞭毛在血液或體液中運動的能力,例如錐蟲(Trypanosoma)。
一些種原生動物能分泌一些物質形成外殼或骨骼以加固體形,例如薄甲藻(Glenodinium)能分泌有機質,在體表形成纖維素板;表殼蟲(Arcella)能分泌幾丁質形成褐色外殼;砂殼蟲(Difflugia)能在體表分泌蛋白質膠,再粘著外界的砂粒形成一砂質殼;有孔蟲可以分泌碳酸鈣形成殼室;而放射蟲類(Radiolaria)可在細胞質內分泌形成幾丁質的中心囊,並有矽質或鍶質骨針伸出體外以支持身體,例如等棘骨蟲(Acanthometra)。
(三)細胞結構及分化
原生動物的細胞質可以分為外質(ectoplasm)和內質(endoplasm)。外質透明清晰、較緻密,內質不透明,其中含有顆粒。由外質還可以分化出一些細微結構,例如腰鞭毛蟲類可分化出刺絲囊(nematocyst);絲孢子蟲類可分化出極囊(polarcapsule);纖毛蟲類可分比出刺絲泡(trichocyst)、毒泡(toxicyst);這些結構在受到刺激時,可放出長絲以麻醉或刺殺敵人,或用以固著,具有攻擊和防衛的功能。一些纖毛蟲類外質還可分化成肌絲(myoneme),肌絲是由許多可收縮的纖維組成,例如鐘形蟲的柄部,外質也參與構成運動細胞器,例如鞭毛、纖毛及偽足等。
內質中包含有細胞質特化形成的執行一定機能的細胞器,例如色素體(chromatophore)、眼點(stigma)、食物泡(foodvacuole)、伸縮泡(contractilevacuole)等以及細胞結構、線粒體、高爾基體等。
原生動物的細胞核位於內質中,除了纖毛蟲類之外,均有一種類型的核。在一個蟲體內,核的數目可以是一個或多個。核的外層是一雙層膜結構,其上有小孔,可使核基質與細胞質相溝通。核膜內包含有核基質、染色質及核仁。如果核內染色質豐富、均勻而又緻密的散布在核內,這種細胞核稱為緻密核(massivenucleus),如果核質較少,不均勻的散布在核膜內,這種核稱為泡狀核(vesicularnucleus)。纖毛蟲具有兩種類型的核,大核(macronucleus)與小核(micronucleus)其大核是緻密核,含有RNA,有表達的功能;小核通常是泡狀核,含有DNA,無表達功能,與纖毛蟲的表型無關,而與生殖有關,也稱生殖核。
(四)運動及運動細胞器
 原生動物
原生動物鞭毛與纖毛從結構與機能上兩者沒有明顯的區別,用電子顯微鏡的觀察證明它們的結構是相同的,只是鞭毛更長(5—200μm)、數目較少(多鞭毛蟲類除外),多數鞭毛蟲具有1—2根鞭毛。纖毛較短(3—20μm)、數目很多。鞭毛與纖毛的直徑是固定的,兩者直徑的差別在0.1—0.3μm之間。鞭毛的擺動是對稱的,包括幾個左右擺動的運動波;纖毛的運動是不對稱的,僅包括一個運動波。
不僅原生動物的鞭毛與纖毛有相似的結構,所有後生動物精子的鞭毛、海綿動物領鞭毛細胞的鞭毛、扁形動物原腎細胞中的鞭毛都有相似的結構,這可作為各類動物之間有親緣關係的一個例證。鞭毛與纖毛除了運動功能之外,它們的擺動,可以引起水流、利於取食、推動物質在體內的流動,另外它們也具有某些感覺的功能。
偽足也是一種運動細胞器,它是由原生質的流動而形成,所以偽足及體形都可改變形狀,偽足可用來在物體表面上爬行運動。偽足的形成與運動是由細胞質內微絲的排列而決定。偽足的形狀可以是葉狀、針狀、網狀等。
(五)營養方式(nutrition)
原生動物包含了生物界的全部營養類型:
1、植物性營養(holophyticnutrition):在植鞭毛蟲類,內質中含有色素體,色素體中含有葉綠素(chlorophyll)、葉黃素(xanthophyll)等,像植物的色素體一樣,利用光能將二氧化碳和水合成碳水化合物,即進行光合作用,自己製造食物。
2、腐生性營養(saprophyticnutrition):孢子蟲類及其他一些寄生或自由生活的種類,能通過體表的滲透作用從周圍環境中攝取溶於水中的有機物質而獲得營養。
3、動物性營養(holozoicnutrition):絕大多數的原生動物還是通過取食活動而獲得營養。例如,變形蟲類通過偽足的包裹作用(engulment)吞噬食物;纖毛蟲類通過胞口、胞咽等細胞器攝取食物,
(六)呼吸作用(respiration)
通過氣體的擴散(diffusion),從周圍的水中獲得氧氣。少數腐生性或寄生的種類,它們生活在低氧或完全缺氧的環境下,有機物不能完全氧化分解,而是利用大量的糖的發酵作用產生很少的能量來完成代謝活動。
(七)水份調節(waterregulation)及排泄(excretion)
淡水生活的原生動物以及某些海產或寄生的種類,隨著取食及細胞膜的滲透作用,相當多的水分也隨之不斷的進入體內,因此需要不斷的將過多的水分排出體外,否則原生動物將會膨脹致死。原生動物的伸縮泡(contractilevacuole)擔任這一功能。在身體的一定部位,細胞質內過多的水分聚集,形成小泡,它由小變大,最後形成一個被膜包圍的伸縮泡,當其中充滿水分後,就自行收縮將水分通過體表排出體外。細胞代謝過程中所產生的含氮廢物,也溶於水中進入伸縮泡排出體外,所以伸縮泡維持著體內水分的平衡併兼有排泄作用。伸縮泡的數目、位置、結構在不同類的原生動物中不同。
(八)生殖(reproduction)
 原生動物
原生動物1、無性生殖:
(1)二分裂(binaryfission)是原生動物最普遍的一種無性生殖,一般是有絲分裂(mitotic),分裂時細胞核先由一個分為二個,染色體均等的分布在兩個子核中,隨後細胞質也分別包圍兩個細胞核,形成兩個大小、形狀相等的子體,二分裂可以是縱裂,如眼蟲;也可以是橫裂,如草履蟲;或者是斜分裂,如角藻(Ceratium)。
(2)出芽生殖(buddingreproduction),實際也是一種二分裂,只是形成的兩個子體大小不等,大的子細胞稱母體,小的子細胞稱芽體。
(3)多分裂(multiplefission),分裂時細胞核先分裂多次,形成許多核之後細胞質再分裂,最後形成許多單核的子體,多分裂也稱裂殖生殖(schizogony),多見於孢子蟲綱。
(4)質裂(plasmotomy),這是一些多核的原生動物,如多核變形蟲、蛙片蟲所進行的一種無性生殖,即核先不分裂,而是由細胞質在分裂時直接包圍部分細胞核形成幾個多核的子體,子體再恢復成多核的新蟲體。
2、有性生殖:
(1)配子生殖(gamogenesis),大多數原生動物的有性生殖行配子生殖,即經過兩個配子的融合(syngamy)或受精(fertilization)形成一個新個體。如果融合的兩個配子在大小、形狀上相似,僅生理機能上不同,則稱為同形配子(isogamete),同形配子的生殖稱同配生殖(isogamy)。如果融合的兩個配子在大小、形狀及機能上均不相同,則稱異形配子(heterogamete),根據其大小不同、分別稱為大配子(macrogamete)及小配子(microgamete),大、小配子從僅略有大小的區別,分化到形態與機能完全不同的精子(sperm)和卵(ovum)。卵受精後形成受精卵,亦稱合子(zygote)。異形配子所進行的生殖稱為異配生殖(heterogamy)。
(2)接合生殖(conjugation),原生動物另一種有性生殖方式是纖毛蟲所具有的接合生殖。
分類
原生動物分布廣,生活於淡水、海水及潮濕的土壤中,也有不少種類營寄生生活。已經記錄的原生動物約有50000種,其中約有20000種為化石種。對於原生動物的分綱動物學家是有爭論的,為方便起見,一般將其分為:鞭毛綱(Mastigophora),肉足綱(Sarcodina),孢子綱(Sporozoa)和纖毛綱(Ciliata)。
鞭毛綱
一、眼蟲Euglena
(一)生境與形態
 原生動物
原生動物(二)表膜的結構
經電子顯微鏡研究,表膜即質膜或稱三分質膜(tripartieplasmalemma)。表膜是由許多螺鏇狀的條紋聯結而成,每一個表膜條紋的一邊有向內的溝(groove),另一邊有向外的嵴(crest)。一個條紋的溝與其鄰接條紋的嵴相關聯(似關節)。眼蟲生活時,表膜條紋彼此相對移動,可能是由於嵴在溝中滑動的結果。表膜下的粘液體(mucusbody)外包以膜,與體表膜相連續,有粘液管通到嵴和溝。粘液對溝嵴聯結的“關節”可能有滑潤作用。表膜覆蓋整個體表、胞咽、儲蓄泡、鞭毛等。使眼蟲保持一定形狀,又能作收縮變形運動。
(三)運動與鞭毛
體前端有一胞口(cytostome).向後連一膨大的儲蓄泡(reservoir),從胞口中伸出一條鞭毛(flagellum)。鞭毛是能動的細胞表面的突起。鞭毛下連有2條細的軸絲(axoneme)。每一軸絲在儲蓄泡底都和一基體(basalbody)相連,由它產生出鞭毛。基體對蟲體分裂起著中心粒的作隊。從一個基體連一細絲(根絲體rhizoplast)至核,這表明鞭毛受核的控制。
鞭毛最外為細胞膜,其內由縱行排列的微管(microtubule)組成。周圍有9對聯合的微管(雙聯體doublets),中央有2個微管。每個雙聯體上有2個短臂(arms),對著下一個雙聯體,各雙聯體有放射輻(radialspokeS)伸向中心。在雙聯體之間又有具彈性的連絲(links)。微管由微管蛋白(tubulin)組成,微管上的臂是由動力蛋白(dynein)組成,具有ATP酶的活性。實驗證明,鞭毛的彎曲,是由於雙聯體微合彼此相對滑動的結果,如圖所示,在彎曲的內、外側放射輻的間隔不改變,彎曲是由於彎曲的外側微管和放射輻對於彎曲內側的微管和放射輻的相對滑動。一般認為臂能使微管滑動(很像肌肉收縮時,橫橋在粗、細肌絲間的滑動),臂上的ATP酶分解ATP提供能量。眼蟲借鞭毛的擺動進行運動。
(四)感光與眼點
 原生動物
原生動物(五)營養
在眼蟲的細胞質內有葉綠林(chloroplast)。葉綠體的形狀(如卵圓形、盤狀、片狀、帶狀、星狀等)、大小、數量及其結構(有無蛋白核及副澱粉鞘)為眼蟲屬、種的分類特徵。眼蟲主要通過葉綠素在有光的條件下利用光能進行光合作用,把二氧化碳和水合成糖類,這種營養方式(與一般綠色植物相同),稱為光合營養(phototrophy)。製造的過多食物形成一些半透明的副澱粉粒(Paramylumgranule)儲存在細胞質中。副澱粉粒與澱粉相似,是糖類的一種,但與碘作用不呈藍紫色.副澱粉粒是眼蟲類特徵之一,其形狀大小也是其分類的依據。在無光的條件下,眼蟲也可通過體表吸收溶解於水中的有機物質。這種營養方式稱為滲透營養(osmotrophy)。
(六)水分調節
眼蟲前端的胞口是否取食固體食物顆粒還有異議。但是已肯定經過胞口可以排出體內過多的水分。在儲蓄泡旁邊有一個大的伸縮泡(contractilevacuole),它的主要功能是調節水分平衡。收集細胞質中過多的水分(其中也有溶解的代謝廢物)。排入儲蓄泡,再經胞口排出體外。
(七)呼吸
眼蟲在有光的條件下,利用光合作用所放出的氧進行呼吸(氧化)作用,呼吸作用所產生的二氧化碳,又被利用來進行光合作用。在無光的條件下,通過體表吸收水中的氧,排出二氧化碳。
(八)生殖
眼蟲的生殖方法一般是縱二分裂,這也是鞭毛蟲綱的特徵之一。先是核進行有絲分裂,在分裂時核膜不消失,基體複製為二,繼之蟲體開始從前端分裂,鞭毛脫去,同時由基體再長出新的鞭毛,或是一個保存原有的鞭毛,另一個產生新的鞭毛。胞口也縱裂為二,然後繼續由前向後分裂,斷開成為2個個體。
在環境不良的條件下。如水池乾涸.眼蟲體交圓,分泌一種膠質形成包囊,將自己包圍起來。剛形成的包囊、可見有眼點,綠色,以後逐流變為黃色,眼點消失,代謝降低,可以生活很久,隨風散布於各處。當環境適合時,蟲體破囊而出,在出囊前進行一次或幾次縱分裂。包囊形成對眼蟲度過不良環境是一種很好的適應世(很多原生動物都能形成包囊)。
多年來用眼蟲進行基礎理論的研究取得不少成果。不僅對遺傳變異理論的探討有意義,而且對了解有色、無色鞭毛蟲類動物間的親緣關係,對了解動、植物的親緣關係都有重要意義。近年來也有用眼蟲作為有機物污染環境的生物指標,用以確定有機污染的程度,另外眼蟲對淨化水的放射性物質也有作用。
二、鞭毛綱的特徵及重要類群
(一)重要特徵
 原生動物
原生動物2、營養方式:光合營養(植物性營養),也稱自養;滲透營養(osmotrophy)(腐生性營養);吞噬營養(phagotrophy)(動物性營養)。滲透營養和吞噬營養也稱異養。
3、繁裂:無性繁殖一般為縱二分裂,有性繁殖為配子結合或整個個體結合。在環境不良的條件下一般能形成包囊
(二)重要類群
根據營養方式的不同.可分為2個亞綱:
1、植鞭亞綱(phytomastigina):一般具有色素體能行光合作用,自由生活在淡水或海水中。種類很多,形狀各異,眼蟲即用於此亞綱。
盤藻(Gonium)):盤藻一般由4個或16個個體排在一個平面上如盤狀。每個個體都具二根鞭毛,有纖維素的細胞壁,有色素體,每個個體都能進行營養和繁殖。
團藻(Volvox):它是由成千上萬的個體構成,排成一空心圓球形,每個個體排列在球的表面形成一層,彼此有原生質橋相連。個體之間有分化,大多數為營養個體,無繁殖能力;少數的個體有繁殖能力,一個個體細胞可形成一個卵,另一個個體細胞可形成很多精子。由精卵結合發育成一新群體。也有少數生殖細胞在春天開始進行孤雌生殖形成子群體。團藻對分析和了解多細胞動物的起源問題很有意義。
夜光蟲(Noctiluca):屬腰鞭毛目,由於海水波動的刺激,在夜間可見其發光,因而得名。蟲體為圓球形,直徑有1mm左右,顏色發紅,細胞質密集於球體的一部分,其內有核,其他部分由細胞質分散成粗網狀,在網眼間交流液體。有2根鞭毛,一根大(又名觸手),一根小。繁殖有分裂法和出芽法,後者在蟲體表面生出很多小個體,脫離母體後發育成新個體。如果這類動物繁殖過剩密住在一起時,可以使海水變色,稱為赤潮,這對漁業危害很大。除了夜光蟲外,溝腰鞭蟲(Gonyaulaxspp.)、裸甲腰鞭蟲(Gymnodiniumspp.)大量繁殖時也能引起赤潮。
還有不少淡水生活的鞭毛蟲能使水污染,如鐘罩蟲(Dinobryon)、尾窩蟲(Uroglena)、合尾滴蟲(Synura)等。但是大多數的植鞭毛蟲是浮游生物的組成部分,是魚類的自然餌料。
2、動鞭亞綱〔Zoomastigina〕:無色素體,其營養方式是異養的。有不少寄生種類,對人和家畜有害。
利什曼原蟲(Leishmania):是一種很小的鞭毛蟲,寄生於人體的有3種。在我國流行的是杜氏利什曼原蟲(L.donovani),它能引起黑熱病,又名黑熱病原蟲。其生活史有兩個階段,一個階段寄生在人體(或狗),另一階段寄生在白嶺子體內。黑熱病主要靠白嶺子傳染。
一個被感染的白嶺子,在其消化道內有很多活動的利什曼原蟲稱為前鞭毛體(promastigote=鞭毛體mastigote=細滴型leptomonad),體梭形(長約15~25um)。當白嶺子叮人時,將原蟲注入到人體,主要在人體內臟的巨噬細胞內發育,鞭毛消失呈一種圓形或橢圓形的小體(約2~3um)稱為無鞭毛體(amastigote=利杜體leishman-Donovan=利什曼型Leishmanial)。這種不活動的無鞭毛體在巨噬細胞里以巨噬細胞為營養),長大,不斷地進行繁殖。繁殖的方法是二分裂。當繁殖到一定數量時,巨噬細胞破裂,這樣無鞭毛體出來又侵入其他的巨噬細胞,如此引起巨噬細胞的大量破壞和增生使肝脾腫大,發高燒貧血,以至死亡。死亡率可達90%以上。
解放前,全國黑熱病患者較多。主要流行於長江以北廣大地區,為我國五大奇生蟲病之一。解放後在黨的領導下,在各流行區建立專門的防治機構,發動民眾從治病、消滅病犬和白嶺子三方面進行防治。現已在全國範圍內基本上控制了黑熱病的流行。
錐蟲(Trypanosoma):多生活於脊椎動物的血液中,其形狀與利計曼原蟲基本相似,只是基體向後移至體後端,鞭毛由基體發出後,沿著蟲體向前伸與細胞質拉成一波動膜。其運動主要靠波動膜及鞭毛,波動膜很適合於在粘稠度較大的環境中運動。錐蟲廠泛存任於各種脊椎動物中,從魚類、兩棲,一直到鳥、哺乳類的馬、牛、駱駝、甚至人,都有錐蟲的寄生。
寄生於人體的錐蟲能侵入腦脊髓系統,使人發生昏睡病,故又名睡病蟲,這種病只發現在非洲,我國還沒發現。在我國發現的錐蟲個要危害馬、牛、駱駝等。對馬危害較重,引起馬蘇拉病,使馬消瘦、體浮腫發熱,有時突然死亡。
隱鞭蟲(Cryptobia):如鰓隱鞭蟲(C.branchialis)寄生於魚鰓。被害的魚常常離群獨游於水面,或靠近岸邊,體色暗黑,不久即死亡。預防主要是注意清塘和選擇優良的魚種下塘。在魚病發生的季節可用硫酸銅、硫酸亞鐵等進行預防和治療。
披髮蟲(Trichonympha):生活在白蟻腸中與白蟻為共生關係。白蟻以木質纖維為食物,但是消化纖維素是靠這些鞭毛蟲的作用。
領鞭毛蟲(Choanoflagellates):
自由生活。在領鞭毛蟲體前端鞭毛基部,有一領狀結構圍繞著鞭毛,它是由細胞質突起形成(見海綿動物的領細胞),後端有一柄,常附於其他物體上營固著生活。如雙領蟲(Diplosiga);營群體生活的如原綿蟲(proterospongia),是一個疏鬆的群體,外周為領細胞,裡邊為變形細胞,埋在一團不定形的膠質中。對於了解海綿動物與原生動物的親緣關係有意義。另一類鞭毛蟲既有鞭毛又有偽足,稱為變形鞭毛蟲(Mastigamoeba),這類動物對探討鞭毛類與肉足類的親緣關係有意義。
肉足綱
 原生動物
原生動物(一)、生境與形態
大變形蟲分布很廣,生活在清水池塘或在水流緩慢藻類較多的淺水中。通常在浸沒於水中的植物上就可找到。
大變形蟲是變形蟲中最大的一種,直徑約200μm~600μm。活的變形蟲體形不斷地改變。結構簡單。體表為一層極薄的質膜。在質膜之下為一層無顆粒、均質透明的外質(ectoplamsm)。此外質之內為內質(endoplasm),內質流動,具顆粒,其中有扁盤形的細胞、核伸縮泡、食物泡及處在不同消化程度的食物顆粒等。內質又可再分為兩部分,處在外層相對固態的稱為凝膠質(plasmagel),在其內部是液態的稱為溶膠質(plamasol)。
(二)運動與偽足
變形蟲在運動時,由體表任何部位都可形成臨時性的細胞質突起,稱為偽足(pseudopodium),它是變形蟲的臨時運動器。偽足形成時.外質向外凸出呈指狀,內質流入其中,即溶膠質向運動的方向流動,流動到臨時的突起前端後又向外分開,接著又變為凝膠質,同時後邊的凝膠質又轉變為溶膠質,不斷地向前流動,這樣蟲體不斷向偽足伸出的方向移動。這種現象叫做變形運動(amoeboidmovement)。變形運動的形式在不同肉足動物有所不同。
變形運動的機理:有人認為凝膠和溶膠的變化是和細胞質的蛋白質收縮有關。在凝膠狀態時蛋白質分子伸展開形成網狀。形成溶膠時蛋白質分子摺疊捲曲起來,形成可溶性的緊密分子。近年來一些學者不斷地從大變形蟲和其他變形蟲的提取物中發現有肌動蛋白和肌球蛋白,通過實驗,現在比較一致的傾向認為,變形蟲運動的機理可能與肌動蛋白和肌球蛋白的相互作用有密切關係。
(三)攝食與營養
偽足不僅是運動器也有攝食的作用。變形蟲主要以單胞藻類、小的原生動物為食。當變形蟲碰到食物時,即伸出偽足進行包圍(吞噬作用phagocytosis),隨著食物也帶進一些水分,形成食物泡(foodvacuole),與質膜脫離進入內質中隨著內質流動。食物泡和溶酶體融合,由溶酶體所含的各種水解酶消化食物,整個消化過程在食物泡內進行。已消化的食物進入周圍的細胞質中,不能消化的物質,隨著變形蟲的前進,則相對地用於後端,最後通過質膜排出體外,這種現象稱為排遺。
變形蟲除了能吞噬固體自物外,還能攝取一些液體物頂,這種現象很像飲水一樣,因此稱稱為胞飲作用(pinocytosis)。即在液體環境小的一些分子(一般是大分子化合物)或離子吸附到質膜表面,使膜發生反應,凹陷下去形成管道,然後在管道內端斷下來形成一些液泡,移到細胞質中,與溶酶體結合形成多泡小體(在一個膜內可有幾個胞飲小泡),經消化後營養物質進入細胞質中。胞飲作用必須有某些物質誘導才能發生。
(四)水分平衡
在內質中可見一泡狀結構的伸縮泡,有節律地膨大、收縮,排出體內過多水分(其中也有代謝廢物),以調節水分平衡。由於變形蟲的細胞質是高滲性的,因此淡水通過質膜的滲透作用不斷地進入體內,同時隨著攝食也帶進一些水分。海水中的變形蟲一般無伸縮泡因為它們生活在與細胞質等滲的海水中,如把它們放在淡水中它們能形成伸縮泡。如果用實驗抑制伸縮泡的活性,則變形蟲膨脹、最後破裂死亡。由此可見伸縮泡對調節水分平衡的重要作用。
(五)呼吸
變形蟲和其他動物一樣需要和利用能量進行呼吸作用。呼吸作用所需O和排出CO,主要通過體表進行。
(六)生殖
變形蟲進行二分裂繁殖,是典型的有絲分裂,一般條件下約進行30分鐘。在分裂過程中,蟲體變圓,有很多小偽足,中期時核膜消失,體伸長,然後分裂分成兩個子細胞。在一般條件下,變形蟲約需3天達到再分裂的大小。
某些變形蟲在不良環境下能形成包囊,偽足縮回,分泌一囊殼,在包囊內蟲體也可進行分裂繁殖,並在適宜的條件下從包囊中出來進行正常生活。
二、肉足綱的特徵重要類群
 原生動物
原生動物1、偽足:偽足有運動和攝食的機能。根據偽足形態結構的不同可分為:①葉狀偽足(lobepodium),為葉狀或指狀,如變形蟲、表殼蟲;②絲狀偽足(filopodium),一般由外質形成細絲狀,有時有分枝。如鱗殼蟲;③根狀偽足(rhizopodium),細絲狀,分枝,分枝又癒合成網狀,如有孔蟲;④軸偽足(axopodium),偽足細長,在其中有由微管組成的軸絲(axialfilament)如太陽蟲、放射蟲.
2、體表:僅有極薄的細胞質膜。細胞常分化為明顯的外質與內質,內質包括凝膠質和溶膠質。蟲體有的為裸露的,有的種類具石灰質或幾了質的外殼,或有矽質的骨骼。
3、繁殖:二分裂,有的種類具有性生殖,形成包囊者極為普遍。生活於淡水、海水,也有寄生的。
(二)肉足綱的重要類群
根據偽足形態的不同可分為二亞綱。
(一)根足亞綱(Rhizopoda) 偽足為葉狀、指狀、絲狀或根狀。大變形蟲即屬於本亞綱。變形蟲的種類很多,它們的偽足都與大變形蟲的相似,生活在水中,也有生活在潮濕土壤中的,有些種類是寄生的,與人生關係密切的,如痢疾內變形蟲。叫溶組織阿米巴,寄生在人的腸道里,能溶解腸壁組織引起痢疾。痢疾內變形蟲的形態,按其生活過程可分為三型;大滋養體、小滋養體和包囊。
所謂滋養體,一般指原生動物攝取營養階段,能活動、攝取養料、生長和繁殖,是寄生原蟲的寄生階段。痢疾內變形蟲的大、小滋養體結構基本上相同。包囊指原生動物不攝取養料階段,周圍有囊壁包圍,富有抵抗不良環境的能力,是原蟲的感染階段。表殼蟲(Arcella)體形如表殼,殼由細胞本體分泌而成,為黃褐色,其上有花紋。殼口向下,指狀偽足由殼口伸出進行運動。砂殼蟲(Difflugia)的殼是由分泌的膠質物混合以自然界中的小砂粒構成的,指狀偽足由殼口伸出。這兩種動物都屬於有殼目,在採到的浮游生物水樣中經常看到。成為浮游生物的組成部分。
有孔蟲:生活在海洋中,大多為底棲。很少生活在淡水中。一般具有石灰質或其他物質形成的外殼,殼多室或單室,形狀多種多樣。偽足根狀,從殼口和殼上的小孔伸出,融合成網狀。生活史較複雜,有世代交替、有性生殖過程中配子具鞭毛。有孔蟲類是古老的動物,從寒武紀到現代都有它的遺蹟,而目數量非常大,現在的海底約有35%是被有孔蟲的殼沉積的軟泥所覆蓋,有孔蟲不但化石多,而且在地層中演變快,不同時期有不同的有孔蟲。根據有孔蟲類的化石不僅能確定地層的地質年代和沉積相,而且還能揭示出地下結構情況,從而對找尋沉積礦產。發現石油、確定油層和擬定油井位置,有著重要的指導作用。
(二)輻足亞綱(Actinopoda) 具有軸偽足,一般體呈球形,多營漂浮生活,生活在淡水或海水中。常見的如太陽蟲、放射蟲。太陽蟲(Artinophrys):多生活在淡水中,細胞質呈泡沫狀態,偽足由球形身體周圍伸出,偽足較長,內有軸絲,這些結構都有利於增加蟲體浮力,適於漂浮生活。也是浮游生物的組成部分,為魚的自然餌料。
放射蟲:這類動物一般具矽質骨骼,身體呈放射狀,在內、外質之間有一幾丁質囊,稱為中央囊,在囊內有一或多個細胞核,在外質中有很多泡,增加蟲體浮力適於漂浮生活。如等輻骨蟲(Acanthometrom).放射蟲也是古老的動物類群,當蟲體死亡後其骨骼沉于海底,也能形成海底沉積。其作用與意義和有孔蟲類相似。
第孢子綱
一、間日瘧原蟲(PlasmodiumvivaxGrassi&Feletti)
瘧原蟲能引起瘧疾,這種病發作時一般多發冷發熱,而且是在一定間隔時間內發作,有些地方叫“打擺了”或“發瘧子”,是我國五大奇生蟲病之一。已描述的瘧原蟲有50多種,其中寄生在人體的瘧原蟲主要有4種:間日瘧原蟲(P.vivax)、三日瘧原蟲(P.malaria)、惡性瘧原蟲(P.flaciparum)和卵形瘧原蟲(P.ovale)。瘧原蟲的分布極廣,遍及全世界。在我國以間日瘧和惡性瘧為最常見,卵形瘧在我國極少發生。在東北、華北、西北等地區主要為間日瘧,三日瘧較少。惡性瘧主要發生在我國西南如雲南、貴州、四川、海南島一帶。過去所說的瘴氣其實就是惡性瘧。這4種瘧原蟲的生活史基本相同。現以間日瘧為例說明瘧原蟲的形態和生活史。
間日瘧原蟲有2個寄主:人和按蚊。生活史複雜,有世代交替現象。無性世代在人體內,有性世代在某些雌按蚊體內,借某些按蚊傳播。
(一)在人體內(進行裂體生殖)
瘧原蟲在肝細胞和紅血細胞內發育。
1、紅血細胞前期(Pre-erythrocyticstage):當被感染的雌按以叮人時,其唾液中瘧原蟲的長梭形子孢子(sporozoite),隨唾液進入人體,隨著血流先到肝臟,侵入肝細胞內,以胞口攝取肝細胞質為營養(這時稱滋養體trophozoite),逐漸增大,成熟後通過復分裂進行裂
 原生動物
原生動物裂殖子成熟後,脹破肝細胞,散發在體液和血液中,一部分裂孩子可被吞噬細胞吞噬,一部分侵入紅血細胞,開始紅血細胞內期的發育。一些學者認為還有一部分又繼續侵入其他肝細胞,進行紅血細胞外期發育。
2、紅血細胞外期(exo-erythrocyticstage):由於此時在紅血細胞內已有瘧原蟲,因此相應地稱為紅血細胞外期。用抗瘧藥物治療,紅血細胞內瘧原蟲雖被消滅,但外期的瘧原蟲並沒有被消滅,因此外期的存在是瘧疾復發的根源。最近許多學者認為紅血細胞外期尚未完全證實,認為瘧疾愈後的復發,是由於子孢子有早髮型或速髮型子孢子tachysporozoite)(引起初期發病)和遲髮型子孢bradysporozoite)(休眠狀態)之分。
3、紅血細胞內期(ervthrocyticstage):由紅血細胞前期所產生的裂殖子,侵入紅血細胞體積漸慚長大,當中有一空泡,核偏在一邊很像一個帶印的戒指,所以稱為環狀體(或環狀滋養體)。在幾小時內環狀體增大,細胞質變得活躍,像變形蟲一樣向各方面伸出偽足,稱阿米巴樣體或大滋養體。此時瘧原蟲攝取紅血細胞內的血紅蛋白為養料,其不能利用的分解產物(正鐵血紅素)成為色素顆粒,積於細胞質內,稱為瘧色素(在肝細胞中的瘧原蟲無瘧色素)。成熟的滋養體幾乎占滿了紅血細胞,由此再進一步發育形成裂殖體,裂殖體成熟後,形成很多個裂殖子,紅血細胞破裂,裂殖子散到血漿中,又各自侵入其他的紅血細胞,重複進行裂體生殖。這個周期所需要的時間在各種瘧原蟲不同,間日瘧需48小時(三日瘧需72小時,惡性瘧需36~48小時)。這也是瘧疾發作所需間隔的時間,即裂殖子進入紅血細胞在其中發育的時間裡瘧疾不發作。當新形成的裂殖子從紅血細胞出來時,由於大量的紅血細胞被破壞,同時裂植子及其代謝產物也放出來、於是引起病人生理上一系列變化,以致表現出發冷發熱等症狀。
這些裂子經過幾次裂體生殖周期以後,或機體內環境對瘧原蟲不利時,有一些裂殖子進入紅血細胞後,不再發育成裂殖體,而發育成大、小配子母細胞。在間日瘧大配於母細胞(雌)較大,有時較正常紅血細胞可大一倍,核偏在蟲體的一邊,較緻密,瘧色素也較粗大。小配子母細胞(雄)較小,核在蟲體的中部,較疏鬆,瘧色素較細小(惡性瘧的配子母細胞形狀如臘腸,雌的兩端稍尖,核較緻密,雄的兩端鈍回,核較疏鬆).這些配子母細胞在人體內如不被接蚊吸去,不能繼續發育。在血液中可能生存30~60天。
(二)在接蚊體內(進行配子生殖和孢子生植)
瘧疾病人紅血細胞內的大、小配子母細胞達到相當密度後,如被接蚊吸去,在蚊的胃腔中進行有性生殖,大、小配子母細胞形成配子。大配子母細胞成熟後稱大配子(或稱雌配子)(macrogamete),形狀變化不大。小配子母細胞的核分裂成幾小塊移至細胞周緣,同時胞質活動,由邊緣突出4~8條活動力很強的毛狀細絲,每個核進入到一個細絲體內,之後鞭毛狀細絲一個個脫離下來形成小配子(或稱雄配子)(microgamete)。小配子在蚊胃腔內遊動與大配子結合(受精)而成合子(zygote)。合子逐漸變長,能蠕動,因此稱動合子(ookinate)。動合子穿入蚊的胃壁,定居在胃壁基膜與上皮細胞之間,體形變圓,外層分泌囊壁,發育成卵囊(oocyst).在一個蚊胃上可有一至數百個卵囊。卵囊里的核及胞質進行多次分裂形成數百至上萬的子孢子,一簇簇地集在卵囊里,成熟後卵囊破裂,子孢子出來,到體腔里可以穿過各種經織,但最多的是到蟻的唾液腺中。在唾液腺子孢子可達20萬之多,子孢子在蚊體生存可超過70天,但生存30~40天后其傳染力大為降低。當蚊再叮人時這些子孢子就隨著唾液進入人體。
與細菌
活性污泥的基本特徵
原生動物
原生動物原生動物與細菌的功能關係
在廢水生物處理系統中將污染物質降解的主要是細菌。原生動物與細菌的關係主要為:①掠食關係,原生動物在食物鏈中處於捕食細菌的作用。一方面,原生動物通過對細菌的捕食,能促進細菌的生長,使細菌的生長能維持在對數生長期,防止種群的衰老,提高細菌的活力,而且原生動物活動產生溶解性有機物質(DOM)可被細菌再利用,促進了細菌的生長;另一方面,原生動物中存在的某些類型(如纖毛類)具有吞食游離細菌的巨大能力,而游離的細菌個體小、密度小,較難沉澱,易被出水帶出而影響水質。有人證明奇觀獨縮蟲在自然水體中1h能吃3萬個細菌。Curds等人在曝氣池中接種纖毛類原生動物,出水大為改善。
②絮凝作用,細菌生長到一定程度後就凝集成絮狀物。這種絮狀物為原生動物提供了著生的環境,反過來絮狀物上的原生動物能加速絮凝過程。Curds等證明纖毛蟲能分泌兩種物質,一種稱為P物質,是一種多糖類碳水化合物;另一種是屬於單糖結構的葡萄糖及阿拉伯糖,表面電荷為負的懸浮顆粒會吸收這種P物質,通過懸浮顆粒表面電荷的改變,就使懸浮顆粒集結起來,形成絮狀物。另外,纖毛蟲還能分泌一種粘液,能把絮狀物再聯結起來。原生動物分泌的粘液對懸浮顆粒和細菌均有吸附能力。這就促進了菌膠團的形成和處理能力的提高。
研究
要了解污水處理過程的變化或處理水的好壞,最好直接研究分析細菌的生長情況。但是對於細菌的觀察、分類鑑定的時間很長,不能及時起指導生產的指示和預報作用。原生動物與細菌之間存在相互依存的功能關係;原生動物個體大,便於觀察;對於環境變化比細菌敏感,更早更容易反映環境的變化。直接觀察原生動物的種類組成、數量、生長和變化狀況,也能反映出細菌的生長和變化情況,即間接地評價污水處理過程和處理效果的好壞,起指導生產的作用。
分內質和外質。外質通常分三層,即胞外膜、外中層和肌絲層。在肌原細胞層里,還有伸縮纖維或肌絲。外質的下面是內質,內質除具胞核外,在比較成熟的蟲體中還有1個。許多簇蟲的蟲體是單個的,也有不少種類常有兩個或更多個蟲體前後連線在一起。最前的個體稱為原始體,後面的個體稱為隨伴體。生活史 很複雜,不同種類簇蟲的生活史各有特點。如尾崎氏絲足蟲的生活史。
系統發生
原生動物是單細胞動物,要討論原生動物的系統發展,必然要涉及到生命起源和細胞起源的問題。從原則上講,在億萬年的發展過程中,首先是由無機物發展到簡單的有機物,由簡單的有機物發展到複雜的有機物,發展成像蛋白質、核酸等那樣複雜的大分子,發展出具有新陳代謝機能、但還無細胞結構的原始生命。恩格斯說:“生命是蛋白體的存在方式,這個存在方式的基本因素在於和它周圍的外部自然界的不斷的新陳代謝,……如果有一天用化學方法製造蛋白體成功了,那末它們一定會顯示生命現象,進行新陳代謝,雖然可能是很微弱的和短暫的。但是這種物體肯定最多也不過具有最低等原蟲的形態,或者還更低得多的形態,……”。現代科學已揭示“蛋白體”主要是由核酸和蛋白質組成的複雜體系,這是最初的生活物質、生命形態。以後又經過漫長的年代,才由非細胞形態的生活物質發展成為有細胞結構的原始生物。由原始生物進化發展,分化出原始的動物和植物。進而發展成現代的形形色色的原生動物。
在原生動物這四綱中哪一類是最原始的?過去有些人認為肉足綱變形蟲這一類動物是最原始的,因為其結構簡單,可是它是吞噬性營養,它需要吃其他原生動物或植物等,所以它不會是最早出現的。纖毛綱結構比較複雜,且為吞噬性營養,也不可能是最早出現的。孢子綱的動物全是寄生的,寄生的種類是由獨立生活的種類發展而來的,因此也不可能是最早出現的。只有鞭毛綱具有3種營養方式,因此一般認為鞭毛綱是原生動物中最原始的一綱。但是在鞭毛綱中到底是哪一類最早出現的,這個問題還有爭論。過去有些人認為最早出現的是有色鞭毛蟲,因為它可以自己製造食物,但因為色素體結構比較複雜,不可能想像最早出現有如此複雜的結構。所以又有些人認為最早出現的不是有色鞭毛蟲,而是無色滲透性營養的鞭毛蟲,因為無色滲透性營養的鞭毛蟲一般構造比較簡單,這種說法看來可以被接受。因為物質的發展是由簡單到複雜,而在單細胞動物出現以前,已經存在著有機物的條件,當然並不是說由現在的無色鞭毛蟲發展來的,而可能是有些類似現在的無色鞭毛蟲,假定把它叫做原始鞭毛蟲。由原始鞭毛蟲,經過漫長的歲月,形成現在的形形色色的鞭毛蟲。現在有人認為領鞭毛蟲是最原始的,它是所有多細胞動物的祖先。
肉足綱也是從原始鞭毛蟲發展來的,因為很多肉足蟲如有孔蟲,其配子具鞭毛,根據生物發生律,說明其祖先是具鞭毛的。又某些種類如變形鞭毛蟲具鞭毛和偽足,這可說明鞭毛蟲與肉足蟲親緣關係密切。纖毛蟲可能是從原始鞭毛蟲發展成鞭毛蟲的過程中,又分出一支形成的,因為纖毛與鞭毛的結構是一致的,說明這二綱的關係較近。孢子綱因全為寄生的,追溯其來源較困難。大致可看出有兩個來源:如瘧原蟲、球蟲,其配子都具鞭毛,可能來源於鞭毛綱,而粘孢子蟲,其營養體全為變形體,可能來源於肉足綱。
對原生動物的系統發展及各綱親緣關係的認識,將隨著科學的發展越來越明確,越來越深入。最後引用恩格斯的一段話作為結束語:“最初發展出來的是無數種無細胞的和有細胞的原生生物,……在這些原生生物中,有一些漸次分化為最初的植物,另一些漸次分化為最初的動物。從最初的動物中,主要由於進一步的分化而發展出無數的綱、目、科、屬、種的動物。”
微生物學辭彙
| 微生物學(microbiology)生物學的分支學科之一。它是在分子、細胞或群體水平上研究各類微小生物(細菌、放線菌、真菌、病毒、立克次氏體、支原體、衣原體、螺鏇體原生動物以及單細胞藻類)的形態結構、生長繁殖、生理代謝、遺傳變異、生態分布和分類進化等生命活動的基本規律,並將其套用於工業發酵、醫學衛生和生物工程等領域的科學。 |
浮游生物
| (plankton ) | 在海洋、湖泊及河川等水域的生物中,自身完全沒有移動能力,或者有也非常弱,因而不能逆水流而動,而是浮在水面生活,這類生物總稱為浮游生物。這是根據其生活方式的類型而劃定的一種生態群,而不是生物種的劃分概念。一般又分為浮遊動物和浮游植物。 |
| 浮遊動物 (zooplantkon) | 原生動物(Protozoa)動物界重最低等的一類真核單細胞動物,個體由單個細胞組成。 輪蟲(rotifer)輪蟲形體微小,長約0.04-2毫米,多數不超過0.5毫米。它們分布廣,多數自由生活,有寄生的,有個體也有群體。 枝角類 (Cladocera)又簡稱“溞類”,水溞,俗稱紅蟲,屬無脊椎動物,甲殼綱,鰓足亞綱。絕大多數生活於淡水、池塘、湖泊、江河中,是魚類的重要食餌,故俗稱“魚蟲”。 橈足類 隸屬於節肢動物門、甲殼綱、橈足亞綱。營浮游與寄生生活,分布於海洋、淡水或半鹹水中。 |
| 浮游植物 (phytoplantkon) | 藍藻門(Cyanophyta)最早的光合放氧生物,對地球表面從無氧的大氣環境變為有氧環境,藍藻門起了巨大的作用。已知藍藻約2000種,中國已有記錄的約900種。藍藻有極大的適應性,分布很廣。 硅藻門(Bacillariophyta)一類真核藻類,多數為單細胞生物。硅藻普遍分布於淡水、海水中和濕土上,為魚類和無脊椎動物的食料。大多水生,幾乎在所有的水體裡都生長,只有極少數生活在陸地潮濕處。 金藻門(Chrysophyta)藻類植物的一門。藻體為單細胞或集成群體,浮游或附著。主要分布在溫度較低的清澈淡水中。 黃藻門(Xanthophyta)一類屬於不等鞭毛類的藻類生物。體類型為單細胞、群體、多核管狀或絲狀體。多數分布於淡水,有些種生活於土壤中,少數種生活于海水中。 甲藻門 (Pyrrophyta)除少數裸型種類外,都有厚的主要是纖維素組成的細胞壁稱為殼。多數為海產種類,少數產於淡水及半鹹水水體中。 綠藻門(Chlorophyta)本門約8600種,從兩極到赤道,從高山到平地均有分布。絕大多數種類產於淡水,少數產于海水,浮游和固著的均有,寄生的引起植物病害;此外還有氣生的種類。 隱藻門(Cryptophyta)隱藻門(Cryptophyta)藻類植物的一門。均為單細胞種類,含有葉綠素a和c,還含有α-胡蘿蔔素,甲藻黃素及藻膽素。體形不對稱,有背腹面。細胞無細胞壁,僅具有柔軟到堅固的周質。僅有隱藻綱1綱,約90種。中國有3種,均發現於淡水。 裸藻門(Euglenophyta)較低等的一個類群。無細胞壁,植物體除個別種類為樹狀群體外,都是具鞭毛遊動型的單細胞體。多數種類含有與綠藻門相似的色素體,有或無蛋白核。世界上約40屬,1000多種。中國現記錄有20屬,約300種。分布較廣。 |

